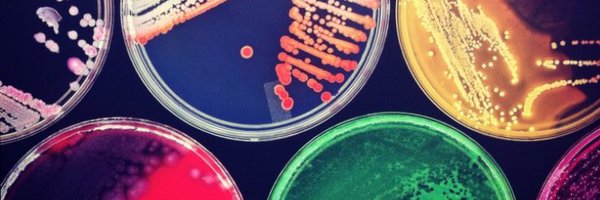
TheHealthcareS1 Profile Banner

Francis Yongblah
@TheHealthcareS1
Followers
1K
Following
7K
Media
350
Statuses
3K
Laboratory Manager. Higher Specialist Scientist Trainee (HSST), in Clinical Microbiology. @PrideAtGOSH network Chair. Musician👨🔬🎷🎻🎹🏳️🌈
London, England
Joined November 2019
🎉Tomorrow is the big day & we're looking forward to celebrating with our finalists! #AHAwards
@IBMScience @ahcsuk @BAPO2 @thecsp
@WGHealthandCare @healthdpt @tennysonCAHPO
@HealthInnovNet @ph_affairs @CSOSue
@BIOS_Orthoptics @RCSLT @BDA_Dietitians
5
5
30
Happy International Nurses’ Day! Thank you to all our amazing nurses for the care and support you provide to patients every day. 💙 With more than 50 different nursing roles in the NHS, no two nursing careers are the same. Learn more: https://t.co/G4mKhtOOzs
#IND2025
46
387
915
This bank holiday, thank you to the biomedical scientists and laboratory staff who keep vital services running 24/7/365. While many take a well-earned break, you remain #AtTheHeartOfHealthcare - supporting diagnosis, treatment and patient care every single day.
0
7
31
🥚🔬🐣 A big thank you to all biomedical scientists delivering egg-cellence in diagnostics this bank holiday weekend. You're truly eggs-traordinary! 😅 🐰🧪 #BiomedicalScience #Eggcellence #FridayFun #ThankYou
0
8
26
A huge thank you to all who submitted entries into the #AHAwards 2025 and a congratulations to all who have been shortlisted as finalists! 👏 You can see the shortlist by going to https://t.co/jk9xpwEqK9 The panel judging will take place on the 31st March. @AHAwards
0
2
7
The shortlist is out here! ➡️ https://t.co/2uX2W7ehpH Congratulations to our finalists & thanks again to all who entered! #AHAwards #AHAwards20
@IBMScience @ahcsuk @BAPO2
@thecsp @WGHealthandCare @healthdpt
@tennysonCAHPO @HealthInnovNet @ph_affairs
@CSOSue @BIOS_Orthoptics
0
7
31
Please consider sharing and completing a sort survey linked to diagnostic testing for Clostridioides difficile in paediatric settings. The survey will be open until midnight Friday 7th March. It would be really helpful to get as wide an input as possible. https://t.co/sUZegifMnB
smartsurvey.co.uk
Please take the time to complete our survey. Your feedback is important.
0
9
5
Today we welcome Professor Elaine Cloutman-Green to share a fantastic blog on how Healthcare Scientists can lead on innovation! Read Elaine's blog in today's #HCSWeek2025 newsletter 👇 https://t.co/8bb0UFUFnx
@girlymicro
0
1
6
Many thanks to the @lgsorch for making sweet, sweet music to put a smile on patients, parents and staffs faces today! What a way to celebrate #lgbtqiahistorymonth @PrideInLondon #uptownfunk 🔊 🆙
0
1
5
Congratulations to Dr Kerrie Davies, Clinical Scientist and Co-chair of Empower Leeds Women, on being awarded an MBE in the King’s New Year Honours! 🏅 This well-deserved recognition celebrates her outstanding contributions to Healthcare Science. 🌟 #MBE #NewYearHonours
1
4
38
Oh wow! Amazing news!
We are pleased to announce Dr. Sarah Pitt as IBMS President Elect as of 1st January 2025. Her Presidency will commence in 2026. Learn more: https://t.co/bZ77z6rr8I
0
0
2
We are pleased to announce Dr. Sarah Pitt as IBMS President Elect as of 1st January 2025. Her Presidency will commence in 2026. Learn more: https://t.co/bZ77z6rr8I
1
8
27
New from @UKHSA AMRHAI Reference Unit and AMR & HCAI Division colleagues: A case of penicillin-resistant group B Streptococcus isolated from a patient in the UK https://t.co/dvvMGrhVc7
#AntimicrobialResistance
academic.oup.com
AbstractObjectives. In England, group B streptococci (GBS; Streptococcus agalactiae) are considered universally susceptible to penicillin. Reports from Afr
0
3
4
Thanks for being happy that I am happy. People are very kind. How we met is a little twist in the book I hope you enjoy. Thanks again xx 💍❤️
709
401
20K
Lovely news! 🎉 Congratulations to @mermhart who has revealed that she recently got married 🥰 More on #TheOneShow now 👉 https://t.co/yGCGLgtxbF
113
443
12K
This #BlackHistoryMonth we’re proud to be celebrating our Black NHS colleagues. This month, we will be sharing stories championing our Black staff and highlighting the work happening across the country to tackle health inequalities. 💙
15
179
295
The overuse and misuse of antibiotics across sectors leads to #AMR, posing a threat to healthcare systems, livelihoods and economies. The #EcoAMR series published today helps to complete the image of this #silentpandemic. Read more 👉 https://t.co/seODYRgtpw
woah.org
This report presents forecasts of global and regional health burden due toAMR using historical estimates from the Global Research on Antimicrobial Resistance (GRAM) Project. This analysis also...
7
40
112